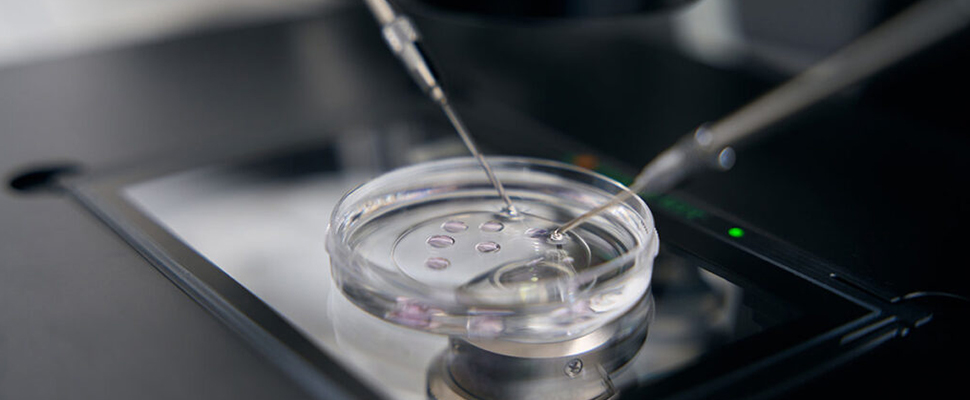

Atendimento exclusivo Ingámed/Inveq
onlineOlá, para que possamos iniciar uma conversa, por favor, preencha os dados abaixo.
aguarde.
Olá, fale com uma de nossas consultoras! Nosso time está pronto para atender você.
Tecnologia em Reprodução Assistida
Na reprodução assistida, a fase de cultura embrionária é uma das mais sensíveis do processo. O ambiente em que os embriões permanecem nas primeiras horas ou dias de desenvolvimento influencia diretamente sua viabilidade, potencial de clivagem e qualidade final. Por isso, a escolha entre cultura embrionária em gotas ou em poços não é apenas uma preferência técnica, mas uma decisão que impacta estabilidade, desempenho e segurança no laboratório.
Este artigo compara os dois métodos, destacando diferenças práticas na manutenção de temperatura, osmolaridade e observação dos embriões. Também mostramos como as placas Ingámed, mesmo sem tratamento superficial adicional, formam gotas estáveis e sem espalhamento — um diferencial importante para rotinas de alta precisão.

Os embriões são extremamente sensíveis a qualquer alteração microambiental. Variações mínimas em temperatura, pH ou osmolaridade podem afetar:
O método de cultura determina como esses fatores serão controlados durante todo o período de incubação. Por isso, embriologistas precisam selecionar a técnica mais adequada ao seu protocolo, ao tipo de incubadora e à rotina da equipe.
A cultura em gotas consiste em pequenos volumes de meio cobertos por óleo mineral. Trata-se de uma técnica amplamente utilizada por oferecer controle microambiental mais preciso.
Como o volume é menor, a gota atinge rapidamente a temperatura ideal dentro da incubadora. Isso reduz riscos de variações térmicas durante a manipulação e garante condições mais estáveis ao embrião.
A cobertura com óleo evita evaporação, preservando osmolaridade e composição do meio. Essa proteção é essencial em cultivos longos ou em laboratórios com maior fluxo de manipulação.
O formato concentrado da gota facilita a visualização, tornando o monitoramento mais rápido e padronizado.
Ideal para rotinas que exigem maior número de pacientes ou ciclos simultâneos.
As placas Ingámed formam gotas estáveis, redondas e sem espalhamento.
Isso traz:

A cultura em poços utiliza volumes maiores de meio em compartimentos individuais ou múltiplos dentro da placa.
Pode ser útil para protocolos que demandam maior diluição de metabólitos ou quando se deseja um ambiente mais amplo ao redor do embrião.
Algumas rotinas preferem reduzir uso de overlay. No entanto, isso exige atenção maior à evaporação e à osmolaridade.
O campo visual do poço permite uma visão geral mais aberta, embora não tão concentrada quanto nas gotas.
Volumes maiores demoram mais para atingir a temperatura precisa e podem sofrer mais variações durante a manipulação.

A seguir, uma visão objetiva para apoiar a decisão técnica:

Após essa comparação, fica claro que a cultura em gotas tende a oferecer maior estabilidade microambiental, especialmente útil em embriões nos estágios iniciais.

As placas Ingámed foram projetadas com foco em segurança, reprodutibilidade e facilidade de uso. Seu design permite:
Esses fatores contribuem diretamente para a viabilidade dos embriões, reduzindo variáveis críticas do processo.

A decisão entre gotas e poços deve considerar:
A escolha entre cultura em gotas e cultura em poços influencia diretamente a qualidade do microambiente e, consequentemente, a viabilidade embrionária. Embora ambos os métodos tenham seus méritos, a cultura em gotas oferece vantagens importantes em termos de temperatura, osmolaridade e observação.
Se o objetivo é alcançar controle microambiental rigoroso e resultados mais previsíveis, a cultura em gotas — especialmente com placas confiáveis — pode ser a melhor escolha para sua rotina.